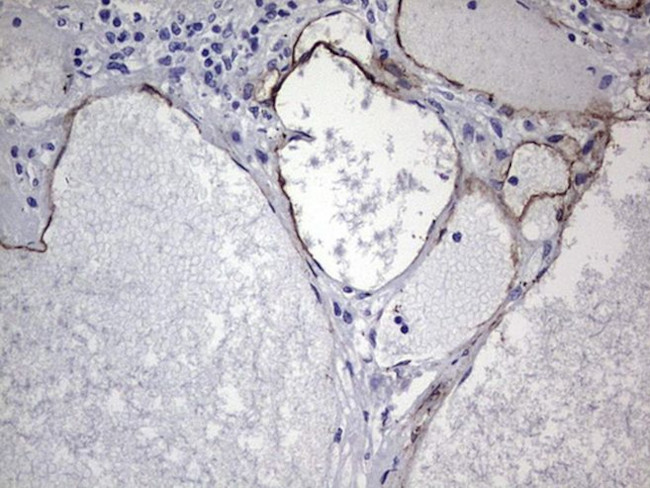
CDH4 Antibody in Immunohistochemistry (Paraffin) (IHC (P))

Search
OriGene
CDH4 Monoclonal Antibody (OTI4F5), TrueMAB™
{{$productOrderCtrl.translations['antibody.pdp.commerceCard.promotion.promotions']}}
{{$productOrderCtrl.translations['antibody.pdp.commerceCard.promotion.viewpromo']}}
{{$productOrderCtrl.translations['antibody.pdp.commerceCard.promotion.promocode']}}: {{promo.promoCode}} {{promo.promoTitle}} {{promo.promoDescription}}. {{$productOrderCtrl.translations['antibody.pdp.commerceCard.promotion.learnmore']}}
产品信息
CF804735
种属反应
宿主/亚型
分类
类型
克隆号
抗原
偶联物
形式
浓度
纯化类型
保存液
内含物
保存条件
运输条件
产品详细信息
For reconstitution, we recommend adding 100 µL distilled water to a final antibody concentration of about 1 mg/mL. To use this carrier-free antibody for conjugation experiments, we strongly recommend performing another round of desalting. (Zeba Spin Desalting Columns, 7KMWCO, 0.5 mL, Product # 89882)
靶标信息
CDH4 is a classical cadherin from the cadherin superfamily. The encoded protein is a calcium-dependent cell-cell adhesion glycoprotein comprised of five extracellular cadherin repeats, a transmembrane region and a highly conserved cytoplasmic tail. Based on studies in chicken and mouse, this cadherin is thought to play an important role during brain segmentation and neuronal outgrowth. In addition, a role in kidney and muscle development is indicated. Of particular interest are studies showing stable cis-heterodimers of cadherins 2 and 4 in cotransfected cell lines. Previously thought to interact in an exclusively homophilic manner, this is the first evidence of cadherin heterodimerization. Three transcript variants encoding different isoforms have been found for this gene.
仅用于科研。不用于诊断过程。未经明确授权不得转售。
篇参考文献 (0)
生物信息学
蛋白别名: Cadherin; cadherin 4, type 1, preproprotein; cadherin 4, type 1, R-cadherin (retinal); Cadherin-4; R-CAD; R-cadherin; Retinal cadherin
基因别名: CAD4; CDH4; R-CAD; RCAD
UniProt ID: (Human) P55283
Entrez Gene ID: (Human) 1002